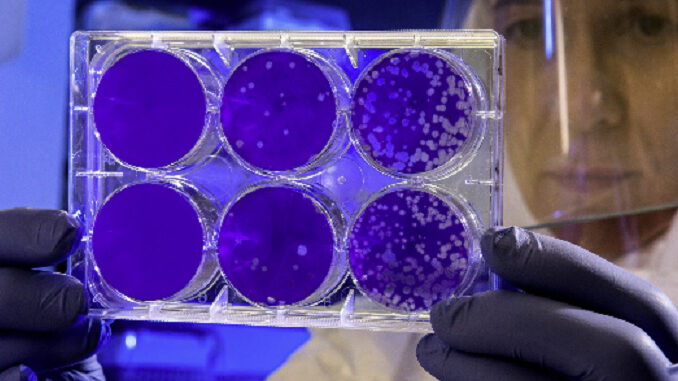

SALUTE Dalla carne agli embrioni umani sintetici con le cellule staminali, la follia in provetta ha oltrepassato ogni limite con pesanti interrogativi legali, etici e scientifici che impongono una doverosa pausa di riflessione. Lo afferma la Coldiretti nel commentare l’esclusiva del Guardian con l’annuncio della biologa Magdalena Zernicka-Goetz dell’Università di Cambridge e del California Institute of Technology sugli embrioni umani sintetici ottenuti utilizzando e riprogrammando le cellule staminali embrionali.
Uno scenario Frankenstein – sottolinea Coldiretti Cuneo – che non può lasciare indifferenti i legislatori a livello mondiale, europeo e nazionale per fermare una pericolosa deriva che sembra non avere confini.
«Si apre la prospettiva di un mondo parallelo fatto in provetta con grande incognita sul futuro dell’umanità. Un percorso iniziato pochi mesi fa con l’annuncio dell’arrivo sulle tavole mondiali dei cibi sintetici a base cellulare ottenuti all’interno di bioreattori per i quali l’Organizzazione Mondiale della Sanità e la FAO hanno individuato ben 53 pericoli potenziali per la salute, dalle allergie ai tumori» dichiara il Presidente di Coldiretti Cuneo, Enrico Nada.
«Una preoccupazione – aggiunge il Direttore di Coldiretti Cuneo, Fabiano Porcu – alla quale si sono aggiunti anche dubbi sul piano ambientale secondo i risultati della ricerca realizzata da Derrick Risner e dai suoi colleghi dell’Università della California a Davis che hanno evidenziato che il potenziale di riscaldamento globale della carne sintetica definito in equivalenti di anidride carbonica emessi per ogni chilogrammo prodotto è da 4 a 25 volte superiore a quello della carne bovina tradizionale».
Un allarme che ha portato alla presentazione in Italia del disegno di legge che vieta la produzione, la commercializzazione e l’uso di cibo artificiale che dovrà ora essere discusso e poi approvato dal Parlamento, con la raccolta da parte della Coldiretti di un milione di firme di cittadini in tutto il Paese. La mobilitazione Coldiretti ha il merito di aver acceso i riflettori su un business in mano a pochi ricchi e influenti nel mondo sul quale è bene fare chiarezza nel rispetto del principio di precauzione. Anche nella Granda la petizione Coldiretti ha raccolto un consenso trasversale, con oltre 15.000 cittadini firmatari e il 60% dei Comuni che hanno espresso il “no” al cibo sintetico.

